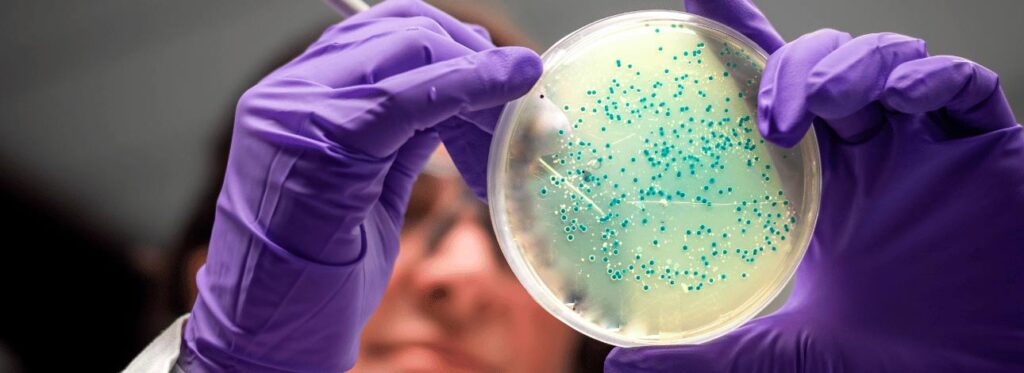
Análise de placas de cultura bacteriana por uma pesquisadora em um laboratório de microbiologia

OMS: Combate à Meningite Diminui e Meta de 2030 Corre Risco
O cenário global reforça um alerta relevante: o combate à meningite diminui em ritmo aquém do necessário para atingir as metas internacionais. Segundo a revista The Lancet Neurology, mais de 250 mil pessoas morreram pela doença em 2023, com cerca de 2,5 milhões de casos registrados, números ainda acima dos objetivos da Organização Mundial da Saúde.
Embora tenha havido uma redução de 63,5% na mortalidade entre 1990 e 2023, o avanço segue insuficiente frente às diretrizes da Organização Mundial da Saúde. Isso, eventualmente, coloca em risco o cumprimento das metas estabelecidas para 2030.
Dados Apontam que Combate à Meningite Diminui no País

Em suma, a análise em evidência na revista científica mostra uma desaceleração no avanço global a partir de 2015. No período entre 2015 e 2023, a redução da mortalidade por meningite alcançou apenas 25,4%, sinalizando perda de ritmo no enfrentamento da doença.
Dessa forma, para que as metas projetadas pela Organização Mundial da Saúde até 2030 sejam viabilizadas, seria necessário sustentar uma queda anual próxima de 8% nos óbitos e de 4,6% na incidência.
No entanto, os dados mais recentes mostram um desempenho abaixo do esperado. Entre 2015 e 2023, as reduções médias anuais ficaram em 4,1% nas mortes e 2,2% na incidência, reforçando o desafio para os sistemas de saúde.
Campanhas de Vacinação são Fundamentais
O avanço registrado nas décadas de 2000 e 2010 teve como principal motor as campanhas de vacinação em larga escala, conforme destaca o relatório. Isso, sobretudo, foi decisivo para reduzir drasticamente a circulação de determinados sorotipos. Principalmente no chamado “cinturão da meningite”, região composta majoritariamente por países de baixa renda.
No entanto, o cenário atual impõe novos desafios. O aumento de casos associados a cepas não contempladas pelas vacinas disponíveis, somado ao avanço da resistência aos antibióticos, tem limitado a eficácia das estratégias tradicionais.
Um Alerta para as Crianças
Os dados reforçam igualmente um ponto crítico: crianças menores de 5 anos seguem como o grupo mais vulnerável à meningite. Em 2023, foram registradas 86.600 mortes nessa faixa etária, o que representa mais de um terço dos óbitos globais pela doença.
Esse cenário se explica, assim, pela maior suscetibilidade a complicações clínicas nesse público. Fatores perinatais e ambientais impactam diretamente a evolução dos casos e aumentam o risco de desfechos graves.
Entre os principais fatores de risco para óbito, destacam-se:
- Baixo peso ao nascer;
- Parto prematuro;
- Poluição do ar.
Referência: Portal G1.
Participe do Canal do WhatsApp da SPX!
Gostou? Clique aqui e acompanhe outros conteúdos da SPX Clínica. Dicas de saúde, novidades e muito mais. Fique por dentro do mundo da saúde!
Últimas Notícias

Ultrassom Contra Vírus Respiratórios: Novo Tratamento?
Pesquisadores estudaram o Ultrassom contra vírus respiratórios, bem como sars-cov-2, H1N1 e outros. Saiba mais sobre os resultados!

IA Aumenta Detecção de Câncer de Fígado Em Até 72%; Veja!
Uma nova tecnologia é capaz de aprimorar a detecção de câncer de fígado em comparação com método tradicional. Saiba mais!

Pandemia de Hantavírus no Brasil: Existe Algum Risco?
Ministério da Saúde confirma sete casos este ano: veja se existe a possibilidade de uma pandemia de Hantavírus no Brasil!

Brasil: Cientistas Criam Sensor Contra o Câncer no Pâncreas
Visando o diagnóstico precoce, cientistas brasileiros desenvolvem um sensor contra o câncer de pâncreas a partir de biomarcadores no sangue

Nova Subvariante da Covid no Brasil? Vírus Já Tem 75 Mutações
Registro de uma nova subvariante da Covid no Brasil e em outros 23 países passa a ser monitorada de perto. Conheça e entenda os riscos!

Gripe em Idosos: Número de Internações Cresce 153% em 2026
Dados de gripe em idosos dispara do esperado e situação liga o alerta de autoridades logo nos primeiros meses do ano!